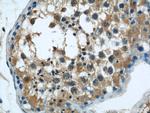
C7orf30 Antibody in Immunohistochemistry (Paraffin) (IHC (P))
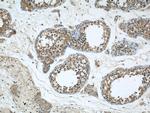
C7orf30 Antibody in Immunohistochemistry (Paraffin) (IHC (P))

Search
Proteintech
C7orf30 Polyclonal Antibody
{{$productOrderCtrl.translations['antibody.pdp.commerceCard.promotion.promotions']}}
{{$productOrderCtrl.translations['antibody.pdp.commerceCard.promotion.viewpromo']}}
{{$productOrderCtrl.translations['antibody.pdp.commerceCard.promotion.promocode']}}: {{promo.promoCode}} {{promo.promoTitle}} {{promo.promoDescription}}. {{$productOrderCtrl.translations['antibody.pdp.commerceCard.promotion.learnmore']}}
产品信息
22838-1-AP
种属反应
已发表种属
宿主/亚型
分类
类型
抗原
偶联物
形式
浓度
规格
纯化类型
保存液
内含物
保存条件
运输条件
产品详细信息
Immunogen sequence: MGPGGRVAR LLAPLMWRRA VSSVAGSAVG AEPGLRLLAV QRLPVGAAFC RACQTPNFVR GLHSEPGLEE RAEGTVNEGR PESDAADHTG PKFDIDMMVS LLRQENARDI CVIQVPPEMR YTDYFVIVSG TSTRHLHAMA FYVVKMYKHL KCKRDPHVKI EGKDTDDWLC VDFGSMVIHL MLPETREIYE LEKLWTLRSY DDQLAQIAPE TVPEDFILGI EDDTSSVTPV ELKCE (1-234 aa encoded by BC012331)
靶标信息
Required for normal mitochondrial ribosome function and mitochondrial translation (PubMed:22238375, PubMed:23171548). May play a role in ribosome biogenesis by preventing premature association of the 28S and 39S ribosomal subunits (Probable). Interacts with mitochondrial ribosomal protein L14 (MRPL14), probably blocking formation of intersubunit bridge B8, preventing association of the 28S and 39S ribosomal subunits (Probable). Addition to isolated mitochondrial ribosomal subunits partially inhibits translation, probably by interfering with the association of the 28S and 39S ribosomal subunits and the formation of functional ribosomes (Probable). May also participate in the assembly and/or regulation of the stability of the large subunit of the mitochondrial ribosome (PubMed:22238376, PubMed:23171548). May function as a ribosomal silencing factor (Probable). [UniProt]
仅用于科研。不用于诊断过程。未经明确授权不得转售。
生物信息学
蛋白别名: Mitochondrial assembly of ribosomal large subunit protein 1; unnamed protein product
基因别名: C7orf30; MALSU1; mtRsfA
UniProt ID: (Human) Q96EH3
Entrez Gene ID: (Human) 115416